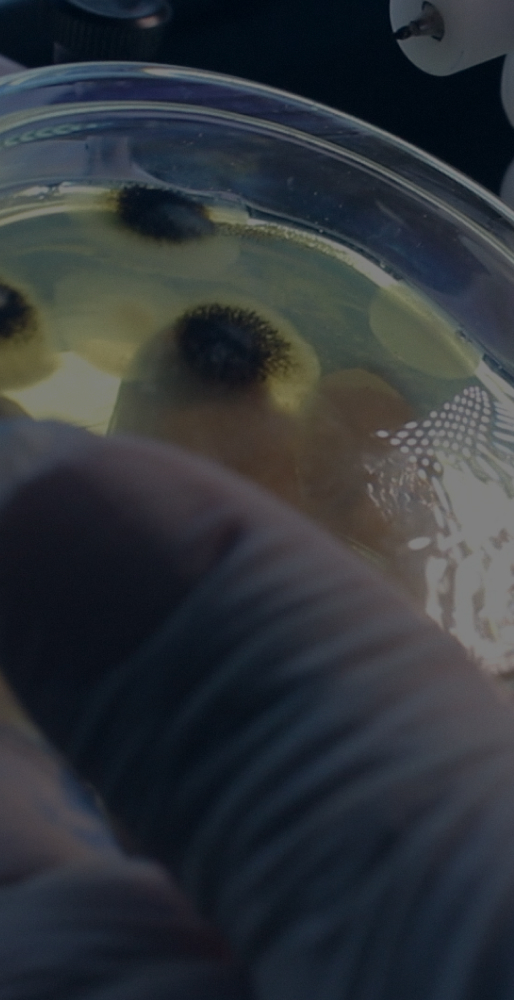
ANÁLISES DE MICRORGANISMOS DO SOLO
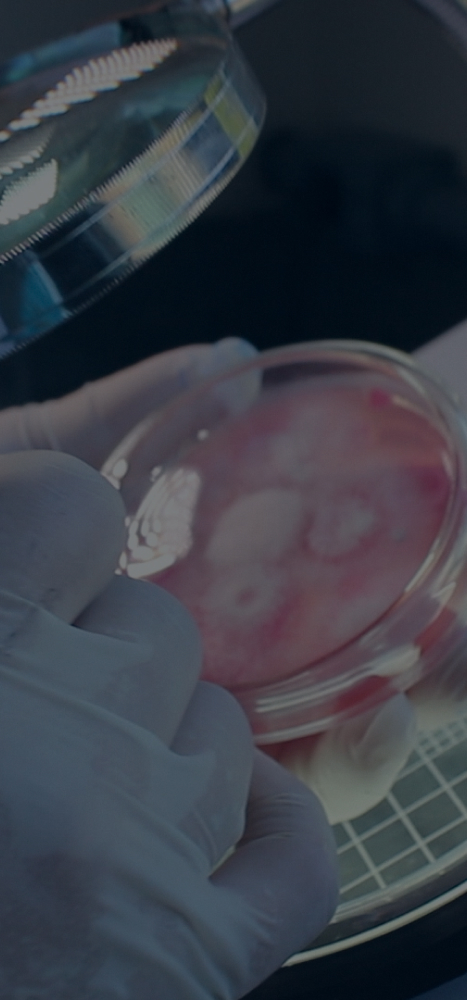
ANÁLISES DE MICRORGANISMOS EM PRODUTOS BIOLÓGICOS  (ON FARM)

ROLAR
PARA BAIXO
QUEM SOMOS
LOREM IPSUM IS SIMPLY DUMMY TEXT OF THE PRINTING AND TYPESETTING INDUSTRY.
LOREM IPSUM HAS BEEN THE INDUSTRY'S STANDARD DUMMY TEXT EVER SINCE THE 1500S
WHEN AN UNKNOWN PRINTER TOOK A GALLEY OF TYPE AND SCRAMBLED IT
TO MAKE A TYPE SPECIMEN BOOK.


ANÁLISESTIPOS DE ANÁLISES
LOREM IPSUM IS SIMPLY DUMMY TEXT OF THE PRINTING AND TYPESETTING INDUSTRY.
CONTATO FALE CONOSCO
Esclareça suas dúvidas, deixe uma mensagem à nossa equipe ou solicite informações e procedimentos.
Preencha corretamente os campos abaixo que em breve retornaremos o contato.
Preencha corretamente os campos abaixo que em breve retornaremos o contato.